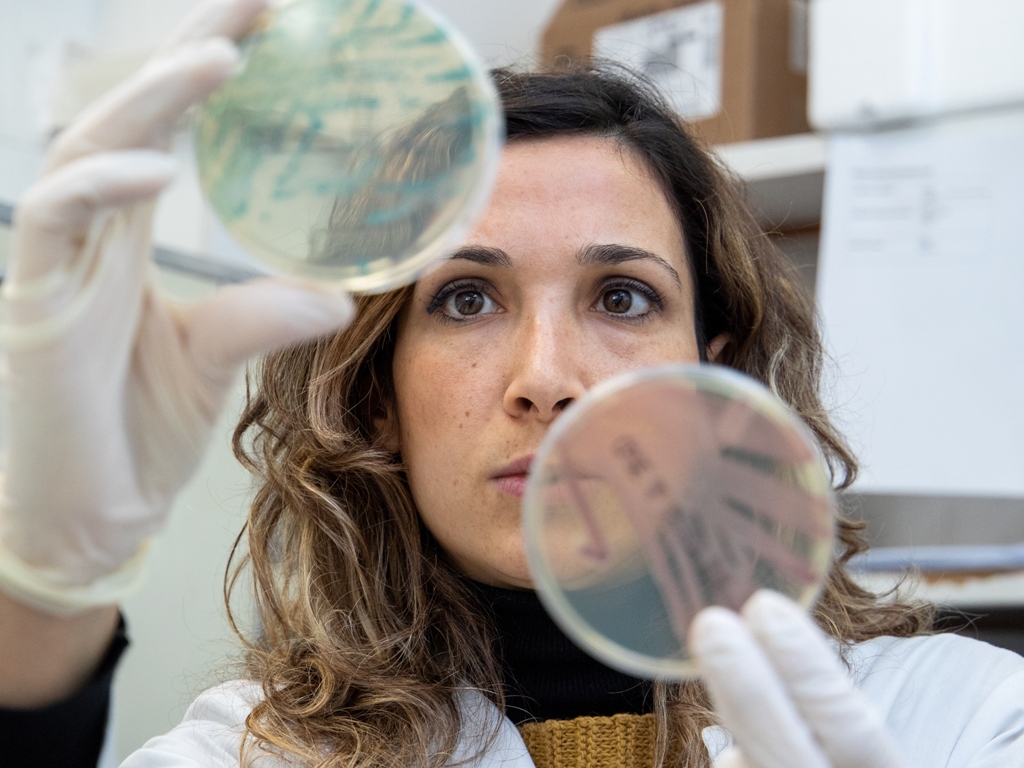

Test Covid Empoli, Lea Srl ha la soluzione
Si fa un gran parlare dei test sierologici per la loro diffusione nella popolazione toscana e italiana per ipotizzare un contagio da Covid-19 (deve essere infatti confermato da un tampone in caso di positività). Non è ancora così conosciuto il nuovo metodo innovativo targato Abbott, ossia la chemioluminescenza, che rientra nella branca dei sierologici ma tra i test quantitativi e non solo qualitativi. Permette infatti di conoscere anche la quantità di anticorpi prodotti con un 99,9% di certezza del risultato.
Test Covid Empoli con Lea Srl
A Empoli Lea Srl - Gruppo Dottor Bartolini, struttura sanitaria accreditata e convenzionata con la Regione Toscana, dal mese di giugno renderà disponibili senza limitazioni o prescrizione i test sierologici e il test di ultima generazione Abbott approvato dal Ministero della Sanità.

Il test SARS-Covid2019 effettuato con macchinario Abbott Architect 4100 ha un'altissima qualità di risposta qualitativa e semiquantitativa sugli anticorpi Igg e Igm. Il test è validato a livello mondiale e indicato dal Sistema Sanitario Nazionale come principale test nazionale.
Dal 15 maggio infatti è partita la seconda fase del monitoraggio voluto dalla Regione Toscana (ordinanze 23, 39 e 54 del 2020). Sarà possibile svolgere test rapidi e di chemioluminescenza anche a imprese e professionisti che non rientravano nella prima ordinanza, ossia di categorie di lavoratori che avevano continuato anche in lockdown a operare. Chi ha riaperto nella Fase 2 può sottoporsi al monitoraggio, così come il singolo cittadino.

C'è di più: il datore dovrà informare i propri dipendenti e collaboratori che intendano sottoporsi volontariamente allo screening sierologico. La Regione Toscana consiglia di stilare un elenco dei lavoratori che sceglieranno di eseguire i test per poi prenotare i test presso i laboratori di analisi convenzionati con la Regione, di cui Lea - Laboratorio Empolese di Analisi è uno dei principali. I test sono eseguiti tramite prelievo venoso.

Per tornare a lavorare e a vivere in sicurezza, rivolgiti a Lea Srl a Empoli. I test Covid saranno aperti a lavoratori o a privati cittadini che vogliono certificare il loro stato di salute. I datti saranno conferiti nell'app predisposta dalla Regione Toscana per seguire lo stato epidemiologico del Covid-19 nella popolazione.
Come prenotare
Il centro Lea ha un numero dedicato per le prenotazioni dei test. Il numero di telefono attivo è il 3713547896. Potete chiamare dal lunedì al venerdì, dalle 8.30 alle 12.30 e dalle 15.00 alle 18.00, oppure potete inviare una mail all'indirizzo emergenza.covid@laboratorioempolese.it
I test potranno essere effettuati anche nei punti Lea decentrati di Certaldo (viale Matteotti, 193) e di Pontedera (via Terracini, 1).

Lea Srl - Laboratorio Empolese Analisi
Telefono attivo: 3713547896
Via J. Chimenti 26
50053 - Empoli
leamedica.it
NUMERO DEDICATO
Telefono attivo: 3713547896
Dal lunedì al venerdì 8.30-12.30
15.00 – 18.00
Mail a EMERGENZA.COVID@LABORATORIOEMPOLESE.IT
Direttore sanitario dott G. Tamburini
Accr Reg tosc. 19445





